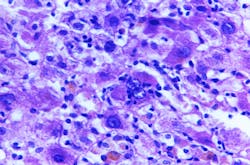

CDC update on children with Acute Hepatitis of Unknown Cause
As of May 18, 36 states and territories have reported 180 pediatric patients under investigation for Acute Hepatitis of Unknown Cause over the past 7 months. This is an increase of 71 from the 109 publicly reported on May 5, according to a statement by the Centers for Disease Control and Prevention (CDC).
While this may appear to be a large increase in patients under investigation over the last two weeks, it’s important to understand that the vast majority of these are what we consider ‘retrospective’ patients. Since CDC’s investigation looks at patients reported back to October of 2021, most of these numbers involve patients that are just now being reported, rather than new cases of hepatitis – so not all are recent, and some may ultimately wind up not being linked to this current investigation. Additionally, there have been no reported deaths since February 2022, and the proportion of patients requiring liver transplants has gone down from 15 percent to 9 percent since May 5.
CDC continues to examine possible causes, including testing for and ruling out some of the viruses that commonly cause hepatitis (hepatitis A, B, C, D, and E). Adenovirus has been detected in nearly half of the children and continues to be a strong lead. Further laboratory tests are being conducted to look more closely at the virus genome and other potential pathogens, such as SARS-CoV-2. In addition, CDC is communicating with key medical groups and continues to provide updated reporting and laboratory guidance for clinicians who may identify hepatitis of unknown cause in children. A Community Outreach and Clinician Activity (COCA) call is scheduled for Thursday, May 19th, where CDC will provide key updates and experts in treating hepatitis will answer clinical questions.
It’s important to note that severe hepatitis in children remains rare. However, the CDC encourages parents and caregivers to be aware of the symptoms of hepatitis – particularly jaundice, which is a yellowing of the skin or eyes – and to contact their child’s healthcare provider with any concern.
CDC will begin posting regular online updates specific to the number of patients under investigation on a weekly basis.